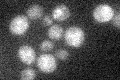

View description
Protein kinase involved in bud growth and assembly of the septin ring, proposed to have kinase-dependent and kinase-independent activities; undergoes autophosphorylation; similar to Kcc4p and Hsl1p
Localization:
Intensity:
Fold change:
Significance:
-
C’ GFP library in SD

bud neckN/A -
N' NOP1pr-GFP in SD

bud neck84.6721 -
N' TEF2pr-mCherry in SD

bud neck35.7234 -
N' NATIVEpr-GFP in SD

bud neck43.255 -
N' TEF2pr-VC and Cyto-VN in SD

bud neck32.3691 -
C’ GFP library in SD+DTT

bud neck28.820.82No -
C’ GFP library in SD+H2O2

bud neck35.91.02No -
C’ GFP library in Starvation Media
cytosol19.10.54No -
C’ GFP library on the background of Pup2-DaMP

bud neck -
C’ GFP library on the background of CCT mutant

bud neck38.04371.08861No
